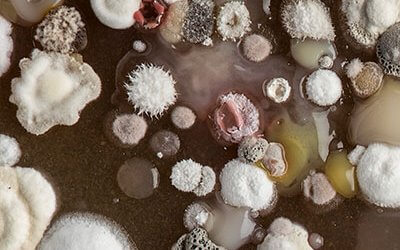

Products and Pathways
Theme 1 - in which we discover new plant and microbial products and metabolic pathways
Read about products and pathwaysImproving our understanding of pathways and production systems of economic and societal value
The Molecules from Nature ISP has four research themes

Theme 1 - in which we discover new plant and microbial products and metabolic pathways
Read about products and pathways
Theme 2 - in which we discover the biological functions and contexts in which valuable products are made and diversified
Read about biological context
Theme 3 - in which we provide systematic understanding of natural products that determine the nutritional value of crops
Read about crop quality
Theme 4 - in which we develop technologies to drive our research and to accelerate its translation into new processes and products
Read about enhanced research capacity